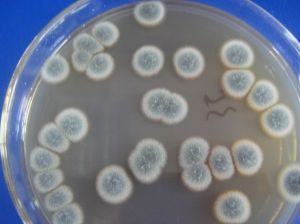
微生物菌劑
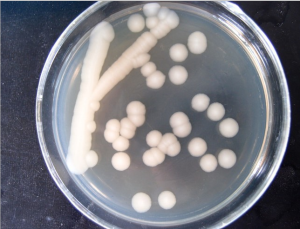
微生物菌劑

簡介
微生物菌劑
微生物菌劑微生物菌劑由能夠防病促生長的多種高效菌株經現代發酵工藝復配而成,通過微生物功能菌株在作物根表、根際和體內定植、繁殖和轉移,充分發揮菌株的促長、固氮、解磷、解鉀、抗病、抗逆和改良土壤等功能,有效預防根腐病、枯萎病、黃萎病、立枯病等多種土傳病害,從而達到增產、防病、改善品質和提高肥料利用率等功能。
適用對象
糧食作物、蔬菜、果樹、花卉、茶樹、中草藥、綠化苗木等各類作物,尤其適合無公害、綠色、有機蔬果的生產。
分類
按劑型可分為:液體、粉劑、顆粒型;
按內含的微生物種類或功能特性可分:為根瘤菌菌劑、固氮菌菌劑、解磷類微生物菌劑、矽酸鹽微生物菌劑、光合細菌菌劑、有機物料腐熟劑、促生菌劑、菌根菌劑、生物修復菌劑等。
按照複合方式分為:微生物菌劑和複合微生物菌劑(JT微生物菌劑)
使用方法
微生物菌劑
微生物菌劑1、基肥或底肥:將本品與有機肥、農家肥或化肥等混合均勻撒入地里,立即犁田耕耙播種。建議用量:大田作物250g/畝,經濟作物500g/畝,果樹10-20g/株。
2、穴施或條施:育苗移栽的作物採用此法,將本肥均勻施入穴和溝內,移栽覆土,可參照基肥。
3、拌種:大粒種子,每畝200g,小粒種子,每畝50-100g。
4、蘸根:稀釋200倍液,浸蘸半小時。
5、溝施追肥:將本品與有機肥、農家肥或細土混合均勻,在樹根四周開溝均勻施入,立即覆土澆水,用量參照基肥。
6、噴霧:稀釋500倍,用紗布過濾後噴施。
注意事項
1、不能與殺菌劑、抗菌類混合施用。
2、隨肥料一起施用時,須隨拌隨用,以免造成肥料融化而影響播肥質量。1/4拌種,3/4拌肥,效果更好。
有效菌種名稱:枯草芽孢桿菌、地衣芽孢桿菌、側孢芽孢桿菌。
作用
1、微生物菌劑可以有效調節作物根部與體內的微生物組成,提高有益微生物數量,抑制有害病菌,抗重茬效果明顯。
2、微生物菌劑可以將土壤中難溶或不溶的鉀、磷轉化為作物直接吸收的速效鉀和有效磷,而且具有較強的固氮作用提高土壤養分的吸收和利用。
3、微生物菌劑能夠產生多種生理活性物質,增強作物抗病、抗旱、抗寒、抗倒伏、促進農作物生長,提高產量,改善品質,提早成熟。
4、微生物菌劑能夠減少化肥和農藥的使用量,降低有害物質的殘留污染。
5、疏鬆土壤,避免板結,改造鹽鹼地。
